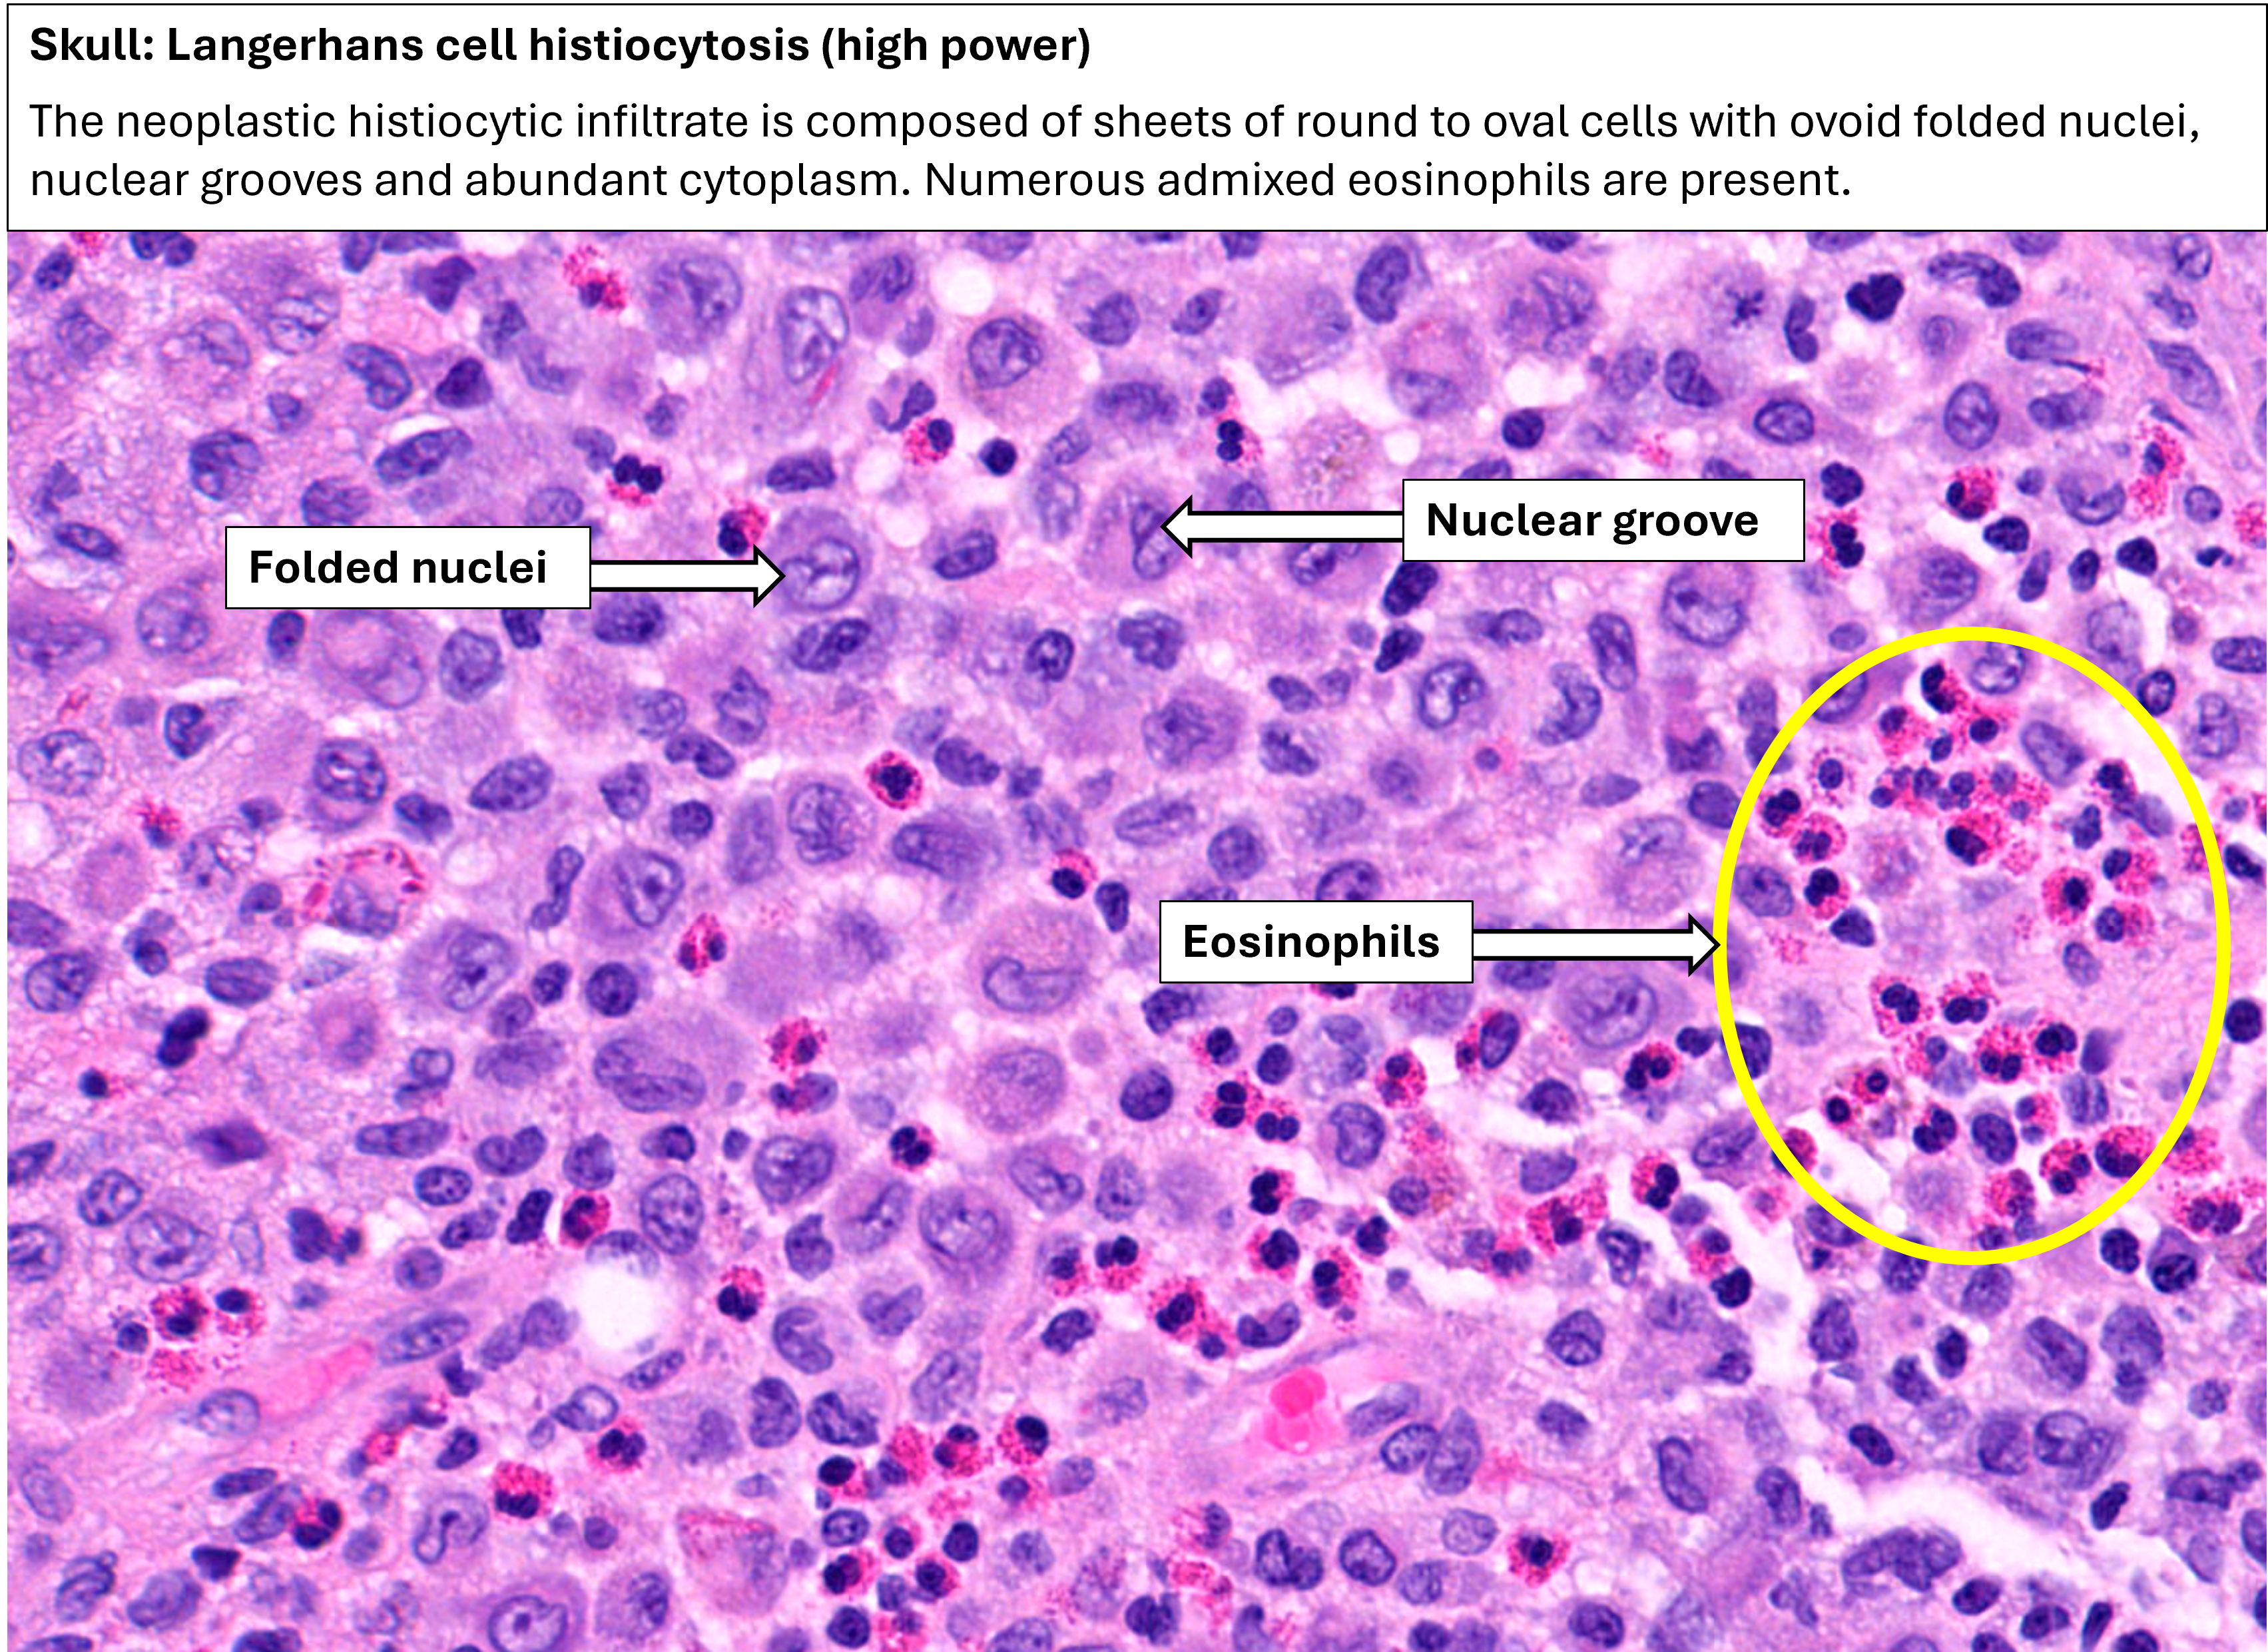

A 16 year old boy with localised pain and tenderness of the skull
The skull bone shows a solitary punched out lytic lesion with a reddish appearance. The lesion shows a double contour or bevelled edge due to asymmetrical involvement of the inner and outer tables.
Histology would reveal Langerhans cells admixed with may eosinophils
Bone (Skull) - Langerhans cell histiocytosis (Gross Pathology)
If you can't play the video, watch it here on Vimeo: https://vimeo.com/1151802912
Bone (skull): Langerhans cell histiocytosis (Virtual microscopy ) - Talking slide
If you can't play the video, watch it here on Vimeo: https://vimeo.com/1151803020
Virtual Pots
Non-neoplastic
- Abscess (02411)
- Fibrocystic change (01146)
- Fibrocystic change (02156)
- Fibrocystic change (02263)
- Fibrocystic change (04796)
- Fibrocystic change (00605)
- Fibrocystic change (05076)
- Paraffinoma (bilateral foreign body reaction) (05255)
- Siliconoma (05563)
- Siliconoma (05564)
- Siliconoma (05567)
- Siliconoma (05568)
- Gynaecomastia, Male (00450)
Neoplastic
- Adenoid cystic carcinoma (03270)
- Adenoid cystic carcinoma (03271)
- Carcinoma (00000)
- Carcinoma (00600)
- Carcinoma (01130)
- Carcinoma (01131)
- Carcinoma (04987)
- Carcinoma (04988)
- Carcinoma (05624)
- Carcinoma with lymph node metastases (02120)
- Carcinoma, fungating (02066)
- Carcinoma, mucoid (03036)
- Carcinoma, mucoid with lymph node metastasis (02377)
- Fibroadenoma (02924)
- Fibroadenoma (04687)
- Fibroadenoma (01139)
- Fibroadenoma (01140)
- Fibroadenoma (04876)
- Fibroadenoma (04698)
- Fibroadenoma, giant (02225)
- Invasive ductal carcinoma (05547)
- Paget's disease (04267)
- Phyllodes tumour (00237)
- Phyllodes tumour (03403)
- Phyllodes tumour (04977)
- Phyllodes tumour, benign (03057)
- Phyllodes tumour, benign (04976)
- Phyllodes tumour, malignant (05193)
Virtual Pots
Aorta and Blood vessels:
- Normal aorta (05036)
- Atheroma with syphilitic aneurysm (02042)
- Atherosclerosis (01163)
- Atherosclerosis (01164)
- Atherosclerosis (01165)
- Atherosclerosis (03888)
- Atherosclerosis (02087)
- Atherosclerosis (04528)
- Atherosclerosis with aneurysm (01691)
- Atherosclerosis with aneurysm (02873)
- Atherosclerosis with aneurysm (04576)
- Atherosclerosis and benign nephrosclerosis (aorta with kidneys) (00414)
- Atherosclerosis and benign nephrosclerosis (aorta with kidneys) (04304)
- Aortic aneurysm (01692)
- Aortic aneurysm (vertebrae) (01693)
- Aortic aneurysm (vertebrae) (01693)
- Aortic aneurysm (aorta with heart) (01559)
- Aortic stenosis with calcification (heart)(01878)
- Dissecting aneurysm (00187)
- Dissecting aneurysm (01695)
- Dissecting aneurysm (heart with aorta)(00246)
- Dissecting aneurysm of the aorta (heart with aorta and kidney)(01369)
- Syphilitic aortitis (heart with aorta) (00703)
- Syphilitic aortitis with aortic incompetence (heart)(01688)
- Iliac vein thrombus (aorta with veins)(01716)
- Inferior vena cava - Thrombus (01717)
- Vein - Varicosity (01775)
- Vein - Thrombus (01718)
Heart:
- Normal heart (02227)
- Normal heart (05173)
- Ascariasis with purulent pericarditis (00203)
- Aortic stenosis with calcification (01878)
- Aortic dissection (heart with aorta) (00558)
- Atrial septal defect (01676)
- Atrial septal defect (01037)
- Aortic and mitral stenosis (01841)
- Aortic stenosis and regurgitation (02809)
- Brown atrophy (00579)
- Brown atrophy (01731)
- Brown atrophy (03744)
- Brown atrophy (00656)
- Cardiac aneurysm, ruptured (01773)
- Congenital hypertrophied cardiomyopathy (03657)
- Congenital cor biloculare, truncus arteriosus and aortic ring (00148)
- Dissecting aneurysm (00558)
- Dissecting aneurysm of the aorta (heart with aorta and kidney) (01369)
- Glycogen storage disease (00365)
- Infarct (03811)
- Infarct, healed (04662)
- Infarct, healed (04655)
- Infective endocarditis (00722)
- Infective endocarditis (01745)
- Infective endocarditis (00615)
- Infective endocarditis (01368)
- Infective endocarditis (01392)
- Infective endocarditis (02779)
- Hypertension with intracerebral haemorrhage and left ventricular hypertrophy (brain, heart, kidney) (00197)
- Left ventricular hypertrophy (01705)
- Left ventricular hypertrophy (01706)
- Left ventricular hypertrophy (00195)
- Left ventricular hypertrophy (00438)
- Left ventricular hypertrophy (00476)
- Left ventricular hypertrophy (04095)
- Left and right ventricular hypertrophy (04183)
- Left ventricular hypertrophy with chronic renal insufficiency (heart and kidney) (03730)
- Nephrosclerosis and left ventricular hypertrophy (kidney & heart)(04096)
- Mitral & aortic stenosis with bacterial endocarditis. infarction of brain (secondary to septic emboli) (02125)
- Myocardial infarct (01708)
- Myocardial infarct (03805)
- Myocardial infarct (04178)
- Myocardial infarct, healed (04655)
- Myocardial Infarct, healed (00706)
- Myocardial infarct with aneurysm (02608)
- Myocardial infarct with aneurysmal dilatation (01885)
- Myocardial infarct with left ventricular hypertrophy (01656)
- Myocardial infarct, ruptured (01710)
- Myocardial infarct with septal rupture (01709)
- Myocardial infarct with thrombus (02095)
- Myocardial infarction, acute (00307)
- Myocardial infarction, acute (03807)
- Myocardial infarction, acute (03814)
- Myocardial infarction, acute (03815)
- Myocardial infarction, subendocardial (04122)
- Myocardial infarction, subendocardial (03201)
- Myocardial infarction, subendocardial (03203)
- Mural thrombus with myocardial infarct (01862)
- Mural thrombus of the left ventricle (01720)
- Pericarditis (01696)
- Pericarditis (01699)
- Pericarditis (02693)
- Pericarditis, purulent (01698)
- Pericarditis, purulent (04447)
- Pericarditis, purulent (heart)(00203)
- Pericarditis with empyema (heart with lungs) (01703)
- Pericarditis with pyaemic lung abscess (lung with heart)(00205)
- Pericarditis, tuberculous (01732)
- Pericarditis, tuberculous (01733)
- Purulent pericarditis with constrictive pericarditis (heart with lungs)(01697)
- Rheumatic heart disease (00478)
- Rheumatic heart disease (01370)
- Rheumatic mitral and aortic stenosis (01742)
- Rheumatic heart disease with mitral and aortic stenosis (00872)
- Rheumatic heart disease with mitral and aortic stenosis (04560)
- Rheumatic valvulitis (04441)
- Subendocardial infarction (03200)
- Toxaemia of pregnancy (heart and liver) (01502)
- Truncus arteriosus, high ventricular septal defect, dysplastic truncal valve (heart with lungs) (04778)
- Ventricular septal defect (01671)
- Ventricular septal defect and brain abscess (00143)
Others:
Virtual Pots
Normal
Infectious
- Abscess (00019)
- Abscess (00020)
- Abscess (00021)
- Abscess (00023)
- Abscess following otitis media (00101)
- Abscess. Lung bronchiectasis (04336)
- Malaria (00033)
- Malaria (Petechial haemorrhage) (04097)
- Meningitis, purulent (00016)
- Meningitis, purulent (02158)
- Meningitis, purulent (04378)
- Meningitis, tuberculous (00024)
- Meningitis, tuberculous (00028)
- Meningitis, tuberculous (01772)
- Meningitis, tuberculous (04090)
- Tuberculosis (00026)
Vascular
- Berry aneurysm, circle of willis - (03299)
- Berry aneurysm, circle of willis (03606)
- Berry aneurysm, circle of willis (03605)
- Cerebral haemorrhage (02033)
- Cerebral haemorrhage (02944)
- Cerebral haemorrhage (02218)
- Cerebral haemorrhage (03570)
- Extradural haemorrhage (01896)
- Extradural haemorrhage (02682)
- Fat embolism (00675)
- Infarct (00013)
- Infarct (00814)
- Infarct (04149)
- Infarct (04534)
- Infarct (05333)
- Intracerebral haemorrhage (00006)
- Intracerebral haemorrhage (00149)
- Intracerebral haemorrhage (02173)
- Intracerebral haemorrhage (02220)
- Intracerebral haemorrhage (02221)
- Intracerebral haemorrhage (03570)
- Subarachnoid haemorrhage (00147)
- Subarachnoid haemorrhage (04389)
- Subarachnoid haemorrhage (04418)
- Subarachnoid haemorrhage due to berry aneurysm (03611)
- Ruptured berry aneurysm with subarachnoid haemorrhage (04393)
- Subdural haematoma, old (00005)
Neoplastic
- Astrocytoma (03721)
- Astrocytoma (03740)
- Craniopharyngioma (04385)
- Ependymoma with hydrocephalus (00050)
- Glioblastoma (02073)
- Glioblastoma (02184)
- Medulloblastoma (00045)
- Meningioma (00062)
- Meningioma (03886)
- Meningioma (--)
- Meningioma (00159)
- Pituitary adenoma (02927)
- Pituitary adenoma (02930)
- Pituitary adenoma (02931)
- Pituitary adenoma (03031)
- Secondary carcinoma (00668)
Others
Virtual Pots
Uterus and Adnexae
Normal
Uterus and fallopian tube
Non-neoplastic
- Endometrial polyp (01765)
- Adenomyosis (05135)
- Adenomyosis (05139)
- Adenomyosis (05140)
- Adenomyosis (05420)
- Adenomyosis (05421)
- Adenomyosis endometriotic cyst of the ovary (05273)
- Bi-cornuate uterus (03831)
- Corpus luteum cyst (01239)
- Endometriotic cyst (04814)
- Endometriotic cyst (05272)
- Endometriosis (00123)
- Hydrosalpinx (01277)
- Nabothian cyst (cervix)(02405)
- Tubal ectopic pregnancy (04264)
- Tubo-ovarian abscess (03437)
- Tubo-ovarian abscess (bilateral) (04411)
- Tubo-ovarian abscess (04773)
- Tubo-ovarian abscess (05400)
- Tubal ectopic pregnancy (01928)
Neoplastic
- Carcinoma of cervix with hydronephrosis (01274)
- Cervical carcinoma (01273)
- Cervical carcinoma (03267)
- Cervical carcinoma (03687)
- Cervical carcinoma (04213)
- Cervical carcinoma (05504)
- Choriocarcinoma (Uterus) (00375)
- Choriocarcinoma (Uterus) (01267)
- Choriocarcinoma (Uterus) (01280)
- Endometrial carcinoma (03323)
- Endometrial carcinoma (03364)
- Endometrial carcinoma (04998)
- Endometrial carcinoma with ovarian carcinoma (03352)
- Hydatidiform mole (Uterus and placenta) (04820)
- Hyatidiform Mole (00162)
- Hydatidiform mole (Uterus) (02639)
- Hydatidiform mole (Uterus) (03168)
- Hydatidiform mole (Uterus) (03168)
- Hydatidiform mole (Uterus) (03185)
- Hydatidiform mole (Uterus) (03662)
- Hydatidiform Mole (Uterus) (03412)
- Invasive hydatidiform mole (02421)
- Invasive hydatidiform mole (02421)
- Leiomyoma (03952)
- Leiomyoma (04172)
- Leiomyoma (04607)
- Leiomyoma (04635)
- Leiomyoma (04999)
- Leiomyoma (05603)
- Leiomyoma with red degeneration (03414)
- Tubal ectopic pregnancy with hydatidiform mole (02394)
- Squamous cell carcinoma of cervix (Uterus) (03268)
- Squamous cell carcinoma of cervix (Uterus) (04039)
- Squamous cell carcinoma of cervix (Uterus) (04982)
Ovary
Non-neoplastic
Neoplastic
- Brenner tumour, malignant (03460)
- Carcinoma (00233)
- Cystadenoma (02347)
- Cystadenoma (02846)
- Clear cell carcinoma (03980)
- Dysgerminoma (02463)
- Fibroma (02801)
- Endometrioid carcinoma (05403)
- Granulosa cell tumour (03213)
- Krukenberg tumour (03409)
- Krukenberg tumour (03628)
- Krukenberg tumour (03629)
- Krukenberg tumour (03818)
- Krukenberg tumour (Ovary, stomach and liver) (01575)
- Mucinous cystadenoma (01250)
- Mucinous cystadenoma (04639)
- Mucinous carcinoma (Mucinous cystadenocarcinoma) (bilateral) (03845)
- Mucinous carcinoma (Mucinous cystadenocarcinoma) (03177)
- Mucinous carcinoma (Mucinous cystadenocarcinoma) (03179)
- Mucinous carcinoma (Mucinous cystadenocarcinoma) (03208)
- Mucinous carcinoma (Mucinous cystadenocarcinoma) (04611)
- Serous carcinoma (Serous cystadenocarcinoma) (00232)
- Serous carcinoma (Serous cystadenocarcinoma) (01224)
- Serous carcinoma (Serous cystadenocarcinoma) (03172)
- Serous carcinoma (Serous cystadenocarcinoma) (03419)
- Serous carcinoma (Serous cystadenocarcinoma) (03440)
- Serous carcinoma (Serous cystadenocarcinoma) (05096)
- Serous cystadenoma (00231)
- Teratoma, cystic (Dermoid cyst) (00497)
- Teratoma, cystic (Dermoid cyst) (03015)
- Teratoma, cystic (Dermoid cyst) (03065)
- Teratoma, cystic (02319)
- Teratoma, cystic (04276)
- Teratoma, cystic (04739)
- Torsion of ovarian cyst with haemorrhagic necrosis (05141)
- Thecoma (02390)
- Thecoma (03196)
Other:
- Placenta praevia and placenta accreta (04824)
- Uterus with tubal ectopic hydatidiform mole (02394)
- Bartholin's cyst (00114)
Virtual Pots
Salivary Gland:
Non-neoplastic
Neoplastic
- Pleomorphic adenoma (03774)
- Pleomorphic adenoma (03524)
- Pleomorphic adenoma (05236)
- Pleomorphic adenoma (04058)
- Warthin Tumour (05315)
Oesophagus:
Non-neoplastic
Neoplastic
- Leiomyoma (03881)
- Squamous cell carcinoma (00458)
- Squamous cell carcinoma (04610)
- Squamous Cell Carcinoma (04912)
- Carcinoma with tracheal fistula (01642)
Stomach:
Non-neoplastic
- Chronic peptic ulcer (01107)
- Chronic peptic ulcer (01568)
- Chronic peptic ulcer (00586)
- Chronic peptic ulcer (01385)
- Chronic peptic ulcer (01388)
- Chronic peptic ulcer (01565)
- Chronic peptic ulcer (02058)
- Chronic peptic ulcer (00483)
- Chronic hypertrophic gastritis (01386)
- Peptic ulcer (healed) (00321)
- Peptic ulcer (healed) (01572)
- Peptic ulcer (healed) (01566)
- Pyloric stenosis (01616)
- Congenital pyloric stenosis (01108)
- Congenital pyloric stenosis (01859)
Neoplastic
- Carcinoma (04754)
- Carcinoma (01989)
- Carcinoma (04931)
- Carcinoma (04612)
- Carcinoma (03353)
- Carcinoma (01581)
- Carcinoma (Linitis plastica) (01576)
- Carcinoma (Linitis Plastica) (03757)
- Carcinoid tumour (04754A)
- Carcinoma with lymph node metastases (02384)
- Gastrointestinal stromal tumour (02925)
- Gastrointestinal stromal tumour (03773)
- Gastrointestinal Stromal tumour (High_risk) (03771)
- Gastrointestinal Stromal tumour (High risk) (03706)
Small Bowel:
Non-neoplastic
- Caecum - Tuberculosis (03120)
- Duodenum - Chronic ulcer with erosion of artery (04551)
- Duodenum - Multiple ulcers (02328)
- Duodenum - Perforated ulcer (02332)
- Intestine - Tuberculosis with perforation (04048)
- Intestine - Intussusception (01626)
- Intestine - Intussusception (01949)
- Intestine - Tuberculosis (04200)
- Ileum - Meckel's diverticulum (04923)
- Ileum - Meckel's diverticulum (00625)
- Ileum - Meckel's diverticulum (02165)
- Ileum - Endometriosis (00123)
- Ileum - Endometriosis (00123)
- Ileum - Tuberculous ulcers (00140)
- Ileum - Enterogenous cyst (02491)
- Liver with Upper GIT and lungs - Ascariasis (01442)
- Omentum - Fat necrosis (01031)
- Small Intestine - Intusussception (02074)
- Small Intestine - Meckel's diverticulum (03861)
- Small Intestine - Tuberculosis (03546)
- Small Intestine - Tuberculosis (01613)
- Small intestine - Tuberculous Ileitis (00452)
- Small Intestine - Acute congestion (Strangulation) (00799)
- Small intestine - Leiomyosarcoma (03634)
Neoplastic
- Duodenum - Ampullary adenocarcinoma with nodal metastases (05513)
- Duodenum - Neuroendocrine tumour (04936)
- Intestine - Gastrointestinal stromal tumour (00582)
- Jejunum - Gastrointestinal stromal tumour (03766)
- Jejunum - Gastrointestinal stromal tumour (05239)
- Jejunum - Gastrointestinal stromal tumour (01987)
- Jejunum - Gastrointestinal stromal tumour (03760)
- Small Intestine - Villous adenoma (04275)
- Small Intestine - Lymphoma (01902)
Appendix and Large Bowel:
Non-neoplastic
- Appendix - Acute appendicitis (01660)
- Appendix - Acute appendicitis (00344)
- Appendix - Acute appendicitics (00454)
- Appendix - Acute appendicitis (01167)
- Appendix - Acute appendicitis (05366)
- Appendix - Acute Appendicitis (03545)
- Appendix - Acute appendicitis with faecaliths (05235)
- Appendix - Acute suppurative appendicitis (05234)
- Appendix - Diverticulosis (00646)
- Large Intestine - Diverticular disease (04359)
- Colon - Crohn's disease (03752)
- Colon - Ulcerative colitis (01798)
- Colon - Ulcerative colitis (01801)
- Colon - Hirschsprung disease (01652)
- Colon - Hirschsprung disease (01653)
- Colon - Tuberculosis (02984)
- Colon - Tuberculosis (04110)
Neoplastic
- Colon - Adenocarcinoma (05084)
- Colon - Adenocarcinoma (01632)
- Colon - Adenocarcinoma (05519)
- Colon - Adenocarcinoma (05080)
- Colon - Adenocarcinoma with lymph node metastases (01195)
- Colon - Polyposis with adenocarcinoma of rectum (01564)
- Colon - Polyposis (05220)
- Colon - Polyposis coli (03708)
- Colon - Polyposis Coli (04806)
- Colon - Polyposis with carcinoma (04756)
- Colon - Polyposis with carcinoma (05043)
- Colon - Polyposis with intussusception (01623)
- Colon - Polyposis with intussusception (01628)
- Intestine - Leiomyoma (03165)
- Intestine - Leiomyoma (03183)
- Intestine_Intravenous infarction. Strangulation (04056)
- Rectum - Adenocarcinoma (01546)
- Rectum - Adenocarcinoma (00751)
- Rectum - Adenomatous Polyp (02921)
Others:
Virtual Pots
Lymph Nodes
Non-neoplastic
- Tuberculosis (Mesenteric) (00850)
- Tuberculosis (Mesenteric) (00191)
- Tuberculosis (Mesenteric) (00192)
- Tuberculosis with primary complex (lung and lymph nodes) (01297)
- Tuberculosis (lung with lymph nodes) (01411)
- Eosinophilic granuloma (Langerhans cell histiocytosis) (03350)
Neoplastic
- Breast carcinoma with nodal metastases (02120)
- Burkitt lymphoma (03390)
- Hodgkin lymphoma (00340)
- Hodgkin lymphoma (00849)
- Large cell lymphoma (02798)
- Leukaemia (00851)
- Lymphoma (04644)
- Lymphoma (02662)
- Lymphoma (01629)
- Metastatic carcinoma from lung (00746)
Spleen and Others
Non-neoplastic
- Congestive splenomegaly (05026)
- Gaucher disease (00836)
- Infarct (04690)
- Malaria (01991)
- Malaria (01999)
- Malaria (01992)
- Infarct (Old) (02094)
- Miliary tuberculosis (00391)
- Miliary tuberculosis (00525)
- Tuberculosis (02290)
- Tuberculosis (02291)
- Tuberculosis (00822)
Neoplastic
- Burkitt lymphoma (Mandible)(00129)
- Hodgkin lymphoma (00376)
- Hodgkin lymphoma (00816)
- Hodgkin lymphoma (01945)
- Hodgkin lymphoma (00741)
- Leukaemia (00829)
- Leukaemia (01937)
- Leukaemia (00830)
- Leukaemia (Kidney & spleen) (02960)
- Leukaemia (Kidney & spleen)(02961)
- Leukaemia (Spleen, bone, kidney and liver)(00832)
- Leukaemia (Liver, spleen, kidney, bone and brain)(02953)
- Leukaemia (Spleen, bone, liver, kidney and brain) (02954)
- Lymphoma (03728)
- Lymphoma (03729)
- Lymphoma (03726)
- Lymphoma (05151)
- Lymphoma (05155)
- Lymphoma (02273)
- Myeloma (skull) (1088)
- Myeloma (vertebrae) (01083)
- Myeloma, multiple (ribs) (01081)
- Non-Hodgkin lymphoma (03488)
- Non-Hodgkin lymphoma (03483)
- Non-Hodgkin lymphoma (00131)
- Secondary carcinoma (02724)
- Thymoma (05306)
Virtual Pots
Gallbladder
- Acute cholecystitis (04780)
- Acute cholecystitis (04798)
- Acute on chronic cholecystitis (05082)
- Acute on chronic cholecystitis (03432)
- Acute on chronic cholecystitis (03763)
- Acute on chronic cholecystitis (03471)
- Acute haemorrhagic cholecystitis (04880)
- Acute haemorrhagic cholecystitis (05032)
- Carcinoma (04766)
- Carcinoma (05031)
- Carcinoma (00585)
- Chronic cholecystitis (00455)
- Chronic cholecystitis (05107)
- Chronic cholecystitis (04791)
- Chronic cholecystitis (gbc)
- Chronic cholecystitis (00456)
- Cholecystitis with cholelithiasis (00217)
- Empyema (05390)
- Gangrenous cholecystitis (05388)
- Gallstone from choledochal cyst (04406)
Liver
Non-neoplastic
- Actinomycosis (00991)
- Actinomycosis (00992)
- Amoebic abscess (02240)
- Amoebic abscess (00881)
- Amoebic abscess (01432)
- Amoebic abscess (multiple) (01509)
- Amyloidosis (01482)
- Amyloidosis (01478)
- Amyloidosis (01479)
- Ascariasis (liver with upper GIT and lungs) (01442)
- Ascariasis (liver with upper GIT and lungs) (01442)
- Biliary atresia (01512)
- Biliary cirrhosis (05444)
- Biliary cirrhosis (05445)
- Biliary cirrhosis (05188)
- Biliary cirrhosis (05458)
- Biliary cystadenoma (05551)
- Choledochal cysts (03166)
- Congenital hepatic fibrosis (01848)
- Cholesterolosis (02853)
- Choledocholithiasis (01469)
- Choledocholithiasis (liver and gallbladder) (02778)
- Cholangitic abscess (04180)
- Cholangitic abscess (04199)
- Chronic venous congestion (01963)
- Chronic venous congestion (01964)
- Chronic venous congestion (01323)
- Chronic venous congestion (04324)
- Cirrhosis (01403)
- Cirrhosis (02091)
- Cirrhosis (00223)
- Cirrhosis (01496)
- Cirrhosis (04846)
- Cirrhosis (05627)
- Cirrhosis (05641)
- Cirrhosis (05642)
- Cirrhosis, cholelithiasis (01155)
- Cirrhosis, cholelithiasis (01499)
- Cirrhosis with oesophageal varices (liver with oesophagus) (01395)
- Cirrhosis and oesophageal varices (oesophagus) (01812)
- Cyst (04487)
- Fatty change (03800)
- Fatty Change (01484)
- Glycogen storage disease (05358)
- Gumma (Tertiary syphilis) (01445)
- Haemochromatosis (04697)
- Haemochromatosis (liver & pancreas) (04713)
- Haemochromatosis with cirrhosis (01490)
- Haemochromatosis, haemosiderosis (02964)
- Haemochromatosis, liver cirrhosis and hepatocellular carcinoma (01127)
- Haemochromatosis with hepatocellular carcinoma (01179)
- Intrahepatic cholelithiasis (01172)
- Metastatic leiomyosarcoma (05265)
- Polycystic disease, adult type (03233)
- Polycystic disease (03045)
- Polycystic disease (00694)
- Polycystic disease (00693)
- Primary sclerosing cholangitis (05619)
- Recurrent pyogenic cholangitis (Secondary to liver flukes) (01471)
- Staphylococcal abscess (01516)
- Syphilis (Hepar lobatum) (02501)
- Toxaemia of Pregnancy (01500)
Neoplastic - Benign
Neoplastic - Malignant
- Acute leukaemia (01522)
- Acute leukaemia (01523)
- Acute leukaemia (01524)
- Acute leukaemia (01520)
- Biliary cystadenocarcinoma (04425)
- Choriocarcinoma of the testis with liver metastases (00545)
- Metastatic gastrointestinal stromal tumour (05264)
- Cholangiocarcinoma (01543)
- Cholangiocarcinoma (00692)
- Cholangiocarcinoma (01995)
- Cholangiocarcinoma (04490)
- Cholangiocarcinoma (04520)
- Cholangiocarcinoma (05464)
- Cirrhosis with hepatocellular carcinoma (05534)
- Cirrhosis with hepatocellular carcinoma (03890)
- Hepatoblastoma (03604)
- Hepatoblastoma (01398)
- Hepatocellular carcinoma, multifocal (02368)
- Hepatocellular carcinoma (00175)
- Hepatocellular carcinoma (01562)
- Hepatocellular carcinoma (04157)
- Hepatocellular carcinoma (02020)
- Hepatocellular carcinoma (03242)
- Hepatocellular carcinoma (04124)
- Hepatocellular carcinoma (04142)
- Hepatocellular carcinoma (04202)
- Hepatocellular carcinoma (05386)
- Hepatocellular carcinoma, diffuse (05023)
- Hepatocellular carcinoma, diffuse (05025)
- Hepatocellular carcinoma, background cirrhosis (05189)
- Hepatocellular carcinoma, background cirrhosis (05190)
- Hepatocellular carcinoma, background cirrhosis (05639)
- Metastatic carcinoma (03490)
- Metastatic carcinoma (01996)
- Metastatic carcinoma (01997)
- Secondary carcinoma (03492)
- Secondary carcinoma (01557)
- Secondary retinoblastoma (02140)
- Secondary neuroblastoma (04163)
Pancreas
- Acute haemorrhagic pancreatitis (01381)
- Acute haemorrhagic pancreatitis (04504)
- Acute haemorrhagic pancreatitis (03588)
- Acute haemorrhagic pancreatitis (00691)
- Acute haemorrhagic pancreatitis (01621)
- Ampullary carcinoma (04033)
- Ampullary carcinoma (05345)
- Adenocarcinoma (00587)
- Adenocarcinoma (05623)
- Adenocarcinoma (05654)
- Adenocarcinoma (04646)
- Adenocarcinoma (05622)
- Adenocarcinoma (04338)
- Adenocarcinoma (04338)
- Fat necrosis (04125)
- Mucinous cystic neoplasm (03777)
- Mucinous cystic neoplasm of distal pancreas (04245)
- Mucinous cystic neoplasm of distal pancreas (04245)
- Neuroendocrine tumour (01375)
- Neuroendocrine tumour (04006)
- Neuroendocrine tumour (03645)
- Neuroendocrine tumour (04325)
- Neuroendocrine tumour (04184)
- Serous cystadenoma (03720)
- Serous cystadenoma (04498)
- Solid pseudopapillary neoplasm of pancreas (04208)
Virtual Pots
Bone Diseases
Non-Neoplastic
- Abscess (vertebrae) (02034)
- Healing fracture (tibia) (00870)
- Osteomyelitis (00413)
- Osteomyelitis (mandible) (00753)
- Osteomyelitis (sternum) (01079)
- Osteoporosis with compression fractures (vertebrae) (00760)
- Pott's disease (vertebrae) (01969)
- Rickets (ribs) (00756)
- Solitary (Simple bone cyst) (fibula) (00378)
- Syphilitic gummata (Sternum) (02712)
- Thalassaemia (skull) (00768)
Neoplastic
- Aneurysmal bone cyst (ulna) (03399)
- Chondrosarcoma (ribs) (00327)
- Chondrosarcoma (rib) (rb)
- Chondrosarcoma (pelvis) (04454)
- Chordoma (sacrum) (03127)
- Ewing sarcoma (clavicle) (03515)
- Ewing sarcoma (clavicle)_(03516)
- Giant cell tumour (knee) (03261)
- Giant cell tumour (humerus) (03590)
- Giant cell tumour (right humerus) (03587)
- Giant cell tumour (tibia) (03709)
- Giant cell tumour with tumour embolus (03357)
- Giant cell tumour with tumour embolus (03358)
- Infarct (fibula) (03959)
- Langerhans cell histiocytosis (skull) (00183)
- Malignant melanoma (foot) (03264)
- Metastatic nasopharyngeal carcinoma (vertebrae) (00210)
- Metastatic cancer (neuroblastoma) (femur) (00765)
- Myeloma, multiple (ribs) (01081)
- Myeloma, multiple (ribs) (01080)
- Myeloma, multiple (ribs) (01082)
- Myeloma (skull) (01088)
- Myeloma (vertebrae) (01083)
- Osteochondroma (03387)
- Osteochondroma (04204)
- Osteochondroma (04861)
- Osteochondroma (03792)
- Osteosarcoma (04772)
- Osteosarcoma (04755)
- Osteosarcoma (03769)
- Osteosarcoma (03911)
- Osteosarcoma (04226)
- Osteosarcoma (knee) (00109)
- Osteosarcoma (tibia) (00110)
- Osteosarcoma (humerus) (03768)
- Osteosarcoma (lower limb) (02769)
- Osteosarcoma (upper limb) (03585)
- Osteoid osteoma (04869)
- Secondary neuroblastoma (femur) (01077)
Joint Diseases
- Bursal cyst (bursa) (05284)
- Bursitis (bursa) (05241)
- Gout (finger) (00758)
- Loose body (hip joint) (05099)
- Osteoarthritis (tibia) (04399)
- Rheumatoid arthritis (tibia) (03517)
- Rheumatoid arthritis (synovitis) (04297)
- Synovial chondromatosis (03693)
- Syphilis charcot joint (knee joint) (01450)
- Tenosynovial giant cell tumour (Nodular tenosynovitis) (04868)
- Tenosynovial giant cell tumour, diffuse type (Villonodular synovitis) (knee) (03502)
Soft tissue diseases
Non-neoplastic
Neoplastic
Lipomatous tumours
- Atypical lipomatous tumour (04017)
- Atypical lipomatous tumour (00462)
- Liposarcoma, retroperitoneum (03221)
- Liposarcoma, myxoid (thigh) (03464)
- Liposarcoma, myxoid (thigh) (03465)
- Liposarcoma, myxoid (02635)
Nerve Sheath Tumours
- Schwannoma (brachial plexus)(02935)
- Schwannoma (Neurilemmoma) (03094)
- Malignant peripheral nerve sheath tumour (Right scapular region) (03607)
Vascular tumours
Others
Virtual Pots
Upper Respiratory Tract
- Nasal polyps (05633)
- Larynx - Tuberculosis (01340)
- Larynx - Tuberculosis (01339)
- Diphtheria (01345)
- Diphtheria (01347)
- Nasopharyngeal carcinoma (01448)
- Nasopharyngeal carcinoma (01918)
- Larynx - Carcinoma (04436)
- Larynx - Carcinoma (02089)
- Larynx - Carcinoma (01342)
- Larynx - Squamous cell carcinoma (04141)
- Larynx - Metastatic carcinoma (02104)
- Larynx - Oedema of glottis (02880)
- Larynx - Airway obstruction by foreign body (fruit) (03602)
- Larynx - Carcinoma with massive cervical lymph node metastases (01341)
- Hypopharynx - Carcinoma with lymph node metastases (03088)
- Pharynx and larynx – Oedema (allergic reaction) (01591)
Lung:
Non-neoplastic
- Abscess (04694)
- Abscesses (02337)
- Abscesses (Multiple) (04588)
- Anthracosis (04548)
- Bronchopneumonia (02856)
- Bronchopneumonia (00542)
- Bronchopneumonia (01301)
- Bronchopneumonia (01310)
- Bronchopneumonia (01312)
- Bronchiectasis (01318)
- Bronchiectasis (01415)
- Bronchietasis (00517)
- Bronchiectasis (01422)
- Bronchiectasis (04462)
- Bronchiectasis (04484)
- Bronchiestasis (04483)
- Bronchiectasis. Brain - Abscess (04336)
- Chronic venous congestion (Brown induration) (01323)
- Chronic venous congestion (00663)
- Chronic venous congestion (01324)
- Emphysema (00710)
- Emphysema (00247)
- Emphysema (04593)
- Emphysema (04554)
- Emphysema (04080)
- Emphysema (01350)
- Foreign body airway obstruction (Peanut) (01322)
- Healed pleuritis (03021)
- Heart with lungs - Thromboembolism (02887)
- Lobar pneumonia (03822)
- Lobar pneumonia (03820)
- Lobar pneumonia (03825)
- Lobar pneumonia (00463)
- Pulmonary embolism (02777)
- Pulmonary embolism (03826)
- Pulmonary tuberculosis (01302)
- Silicosis (01810)
- Silicosis (01809)
- Silicosis (01808)
- Silicosis (03176)
- Silicosis (03630)
- Tuberculous bronchopneumonia with cavitation (00385)
- Tongue with larynx - Ulceration tuberculosis (01337)
- Tuberculosis with cavitation (01828)
- Tuberculosis with cavitation (advanced) (01303)
- Tuberculosis (lngt)
- Tuberculosis (01314)
- Tuberculosis (02122)
- Tuberculosis with primary complex (lung and lymph nodes) (01297)
- Tuberculosis (lung with lymph nodes) (01411)
- Tuberculosis (lung and larynx) (01288)
- Tuberculosis (lung with heart) (01596)
- Tuberculosis, primary complex (lung with heart) (01299)
Neoplastic
- Adenocarcinoma (04535)
- Bronchogenic carcinoma (01414)
- Bronchogenic carcinoma (04688)
- Carcinoma (01038)
- Carcinoma (02278)
- Mesothelioma (05085)
- Mesothelioma (05040)
- Mesothelioma (05064)
- Mesothelioma (05065)
- Mesothelioma (05088)
- Metastatic carcinoma (02135)
- Metastatic carcinoma (01406)
- Metastatic carcinoma (01412)
- Metastatic carcinoma (02008)
- Metastatic choriocarcinoma (03256)
VIRTUAL POTS
NON-NEOPLASTIC
- Accessory tragus (ear) (02574)
- Calcinosis cutis (05232)
- Carbuncle (05242)
- Carbuncle (05243)
- Carbuncle (03320)
- Cutaneous horn (05589)
- Epidermal cyst (05075)
- Epidermal cyst (05663)
- Fistula in ano (05052)
- Gangrene (foot) (05097)
- Gangrene (toes) (05632)
- Keloid (05542)
- Keloid (05648)
- Keloid (05650)
- Keloid (elbow) (05645)
- Syphilitis tertiary (Gumma) (01449)
- Tuberous xanthoma (01063)
- Tumoral calcinosis (hip region) (03328)
- Ulcer (01041)
NEOPLASTIC
BENIGN
- Cavernous haemangioma (02630)
- Cavernous haemangioma (02631)
- Cavernous haemangioma (02633)
- Cavernous haemangioma (02634)
- Cavernous haemangioma (02632)
- Dermatofibroma (05467)
- Dermatofibrosarcoma protuberans (00425)
- Dermatofibrosarcoma protuberans (00426)
- Dermatofibrosarcoma protuberans (03130)
- Dermatofibrosarcoma protuberans (03134)
- Fibroepithelial polyp (05658)
- Lipoma (thigh) (04466)
- Lipoma (04047)
- Neurofibromatosis (01026)
- Neurofibroma (01056)
- Pilomatrixoma (04955)
- Schwannoma (Neurilemmoma) (03783)
- Schwannoma (Neurilemmoma) (02829)
- Subcutaneous tissue lymphangioma (00164)
MALIGNANT
- Basal cell carcinoma (03283)
- Dermatofibrosarcoma protuberans with malignant transformation (00332)
- Dermatofibrosarcoma protuberans with malignant transformation (00333)
- Malignant melanoma (foot) (00372)
- Malignant melanoma (foot) (03264)
- Sebaceous carcinoma (scalp) (01067)
- Sebaceous carcinoma (01971)
- Squamous cell carcinoma (verrucous) (heel) (03562)
- Squamous cell carcinoma (04606)
- Squamous cell carcinoma (leg) (00711)
- Squamous cell carcinoma (leg) (00712)
- Squamous cell carcinoma (verrucous) (03671)
- Squamous cell carcinoma (maxilla) (05138)
OTHERS
Virtual Pots
Thyroid
Non-neoplastic
- Graves disease (03454)
- Graves disease (03455)
- Graves disease (05057)
- Graves disease (00500)
- Hashimoto thyroiditis (00896)
- Hashimoto thyroiditis (01793)
- Hashimoto thyroiditis (05584)
- Hashimoto thyroiditis (05583)
- Multinodular goitre (05013)
- Multinodular goitre (05528)
- Multinodular goitre (00618)
- Multinodular goitre (00885)
- Multinodular goitre (00431)
Neoplastic
- Follicular adenoma (02259)
- Follicular adenoma (02615)
- Follicular carcinoma (00357)
- Papillary carcinoma (03355)
- Papillary carcinoma (05122)
- Papillary carcinoma (05121)
- Primary carcinoma (00897)
- Medullary carcinoma (04051)
- Medullary carcinoma (03285)
- Thyroid with larynx and tongue: Primary carcinoma (03894)
- Thyroid & lung: Primary thyroid carcinoma with lung secondaries (02570)
Parathyroid
Adrenal
- Adrenal cortical adenoma (Adrenocortical adenoma) (01864)
- Adrenal cortical adenoma (Adrenocortical adenoma) (02613)
- Adrenal cortical adenoma (Adrenocortical adenoma) (03937)
- Adrenal cortical adenoma (Adrenocortical adenoma) (04870)
- Adrenal cortical adenoma_(Adrenocortical adenoma) (03583)
- Adrenal cortical adenoma (Adrenocortical adenoma) (03961)
- Adrenal cortical adenoma (Adrenocortical adenoma) (02831)
- Adrenal cortical carcinoma (Adrenocortical adenoma) (00862)
- Adrenal cortical carcinoma (Adrenocortical adenoma) (00864)
- Adrenal cortical carcinoma (Adrenocortical carcinoma) (02569)
- Adrenal cortical carcinoma (Adrenocortical carcinoma) (03394)
- Adrenal cortical carcinoma (Adrenocortical carcinoma) (03699)
- Adrenal haemorrhage, massive (Waterhouse-Friderichsen syndrome) (00858)
- Ganglioneuroma (05391)
- Ganglioneuroma (05313)
- Ganglioneuroma (00096)
- Histoplasmosis (03244)
- Histoplasmosis (03572)
- Histoplasmosis (03575)
- Histoplasmosis (00946)
- Histoplasmosis (03246)
- Neuroblastoma (04154)
- Neuroblastoma (00108)
- Neuroblastoma (01835)
- Neuroblastoma (04658)
- Neuroblastoma (04673)
- Neuroblastoma (03569)
- Phaeochromocytoma (05367)
- Phaeochromocytoma (04703)
Others
Virtual Pots
Kidney, Ureters and Bladder
Non-neoplastic
- Atherosclerosis and benign nephrosclerosis (Aorta with kidneys) (04304)
- Acute pyelonephritis (00951)
- Acute rejection (transplanted) (03144)
- Atherosclerosis and benign nephrosclerosis (Aorta with kidneys) (00414)
- Acute tubular necrosis (00282)
- Acute tubular necrosis (04280)
- Acute tubular necrosis (02983)
- Amyloidosis (00974)
- Atrophy (04320)
- Atrophy of one kidney (03879)
- Benign nephrosclerosis (00572)
- Benign nephrosclerosis and diabetic glomerulosclerosis (00144)
- Benign nephrosclerosis and diabetic glomerulosclerosis (01908)
- Benign nephrosclerosis and diabetic glomerulosclerosis (01909)
- Calculus (00913)
- Chronic pyelonephritis (02121)
- Chronic pyelonephritis (04094)
- Cortical necrosis (02163)
- Cortical necrosis (00139)
- Cortical necrosis (00279)
- Congenital polycystic disease (04511)
- Diverticulum (00761)
- End-stage kidney (00968)
- End-stage kidney (02079)
- End stage kidney (01904)
- End-stage kidney (00199)
- End stage kidney (00965)
- End stage kidney (02101)
- Hydronephrosis with staghorn calculus (00295)
- Hydronephrosis with staghorn calculus (00296)
- Hydronephrosis with staghorn calculus (02105)
- Hydronephrosis with tuberculosis (02019)
- Hydronephrosis with ureteric calculus (01921)
- Hydronephrosis with ureteric calculus (00293)
- Hydronephrosis with ureteric calculus (02149)
- Hydronephrosis with ureteric calculus (00292)
- Hydronephrosis with nephrolithiasis and chronic pyelonephritis (00294)
- Hydronephrosis with nephrolithiasis and chronic pyelonephritis (00297)
- Horseshoe kidney (00261)
- Infarct (01816)
- Infarct (00277)
- Nephroblastoma (02302)
- Nephroblastoma (05416)
- Nephroblastoma (03427)
- Nephroblastoma (04076)
- Nephroblastoma (05489)
- Nephrotic syndrome (membranous glomerulopathy) (03240)
- Polyarteritis nodosa (Kidney, intestine and liver) (00976)
- Polycystic disease, adult type (Kidney, liver and pancreas) (03233)
- Polycystic disease (Kidney and liver) (03045)
- Polycystic disease (00969)
- Polycystic disease (00268)
- Polycystic disease (00265)
- Polycystic disease (00267)
- Polycystic disease (01361)
- Polycystic disease (Liver, pancreas and kidney) (03234)
- Pyaemic abscess (01818)
- Renal adenoma (00941)
- Simple renal cyst (00287)
- Simple renal cyst (00285)
- Simple renal cyst (00288)
- Staghorn calculus (02132)
- Tuberculous pyelonephritis (02266)
- Tuberculous pyelonephritis (00397)
- Tuberculous pyelonephritis (03837)
- Tuberculosis (03925)
- Tuberculosis (04747)
- Tuberculosis (04738)
- Xanthogranulomatous pyelonephritis (03849)
Neoplastic
- Chronic myeloid leukaemia (00931)
- Nephroblastoma (01197)
- Renal cell carcinoma (03080)
- Renal cell carcinoma (03912)
- Renal cell carcinoma (05202)
- Renal cell carcinoma (05475)
- Renal cell carcinoma (05665)
- Renal cell carcinoma (00347)
- Renal cell carcinoma (00918)
- Renal cell carcinoma (03180)
- Renal cell carcinoma (03335)
- Renal cell carcinoma (04640)
- Renal cell carcinoma (05201)
- Renal pelvis urothelial carcinoma (03654)
- Renal pelvis urothelial carcinoma (00919)
- Renal pelvis urothelial carcinoma (04723)
- Renal pelvis urothelial carcinoma with hydronephrosis (00925)
- Squamous cell carcinoma (00907)
- Squamous cell carcinoma (04790)
- Urothelial carcinoma (02836)
- Urothelial carcinoma (00906)
- Urothelial carcinoma (00137)
- Urothelial carcinoma (03110)
- Urothelial carcinoma (01795)
- Urothelial carcinoma (00531)
- Urothelial carcinoma (00521)
- Urothelial carcinoma (00905)
- Urothelial carcinoma (00521)
- Urothelial carcinoma of renal pelvis and ureter (04201)
- Urothelial carcinoma of bladder with hydronephrosis of kidney and renal calculus (00909)
- Urothelial carcinoma (Ureter with kidney) (05225)
Prostate, Testis
- Benign prostatic hyperplasia with bladder hypertrophy (Bladder & prostate) (01823)
- Benign prostatic hyperplasia with bladder hypertrophy (Bladder & prostate)(01211)
- Benign prostatic hyperplasia (04011)
- Benign prostatic hyperplasia (01832)
- Benign prostatic hyperplasia (02392)
- Benign prostatic hyperplasia (04037)
- Benign prostatic hyperplasia (03041)
- Benign prostatic hyperplasia with hydroureter and hydronephrosis (02059)
- Benign prostatic hyperplasia (Prostate and urinary bladder) (02086)
- Benign prostatic hyperplasia with hydroureter and hydronephrosis (01221)
- Benign prostatic hyperplasia with hydroureter and hydronephrosis (00654)
- Benign prostatic hyperplasia with hydroureter and hydronephrosis (04704)
- Choriocarcinoma of the testis with liver metastases (Testis & liver)(00545)
- Embryonal carcinoma (01181)
- Embryonal carcinoma (00526)
- Hydrocoele (02447)
- Hydrocoele (03913)
- Hydrocoele (02808)
- Oedema (01942)
- Prostatic carcinoma (00176)
- Prostatic carcinoma (01210)
- Strangulation due to torsion of spermatic cord (00157)
- Seminoma (00384)
- Seminoma (02832)
- Seminoma (00523)
- Seminoma (03846)
- Seminoma (03331)
- Seminoma (04848)
- Tuberculous epididymitis (01105)
- Tuberculosis (01188)
- Tuberculosis (00943)
- Tuberculosis (00944)
- Torsion (Testis & epididymis)(05521)
- Torsion (Testis & epididymis)(05522)
- Teratoma (02354)
Penis, Scrotum
- Home
- Virtual Pathology Museum
- Skull – Langerhans Cell Histiocytosis